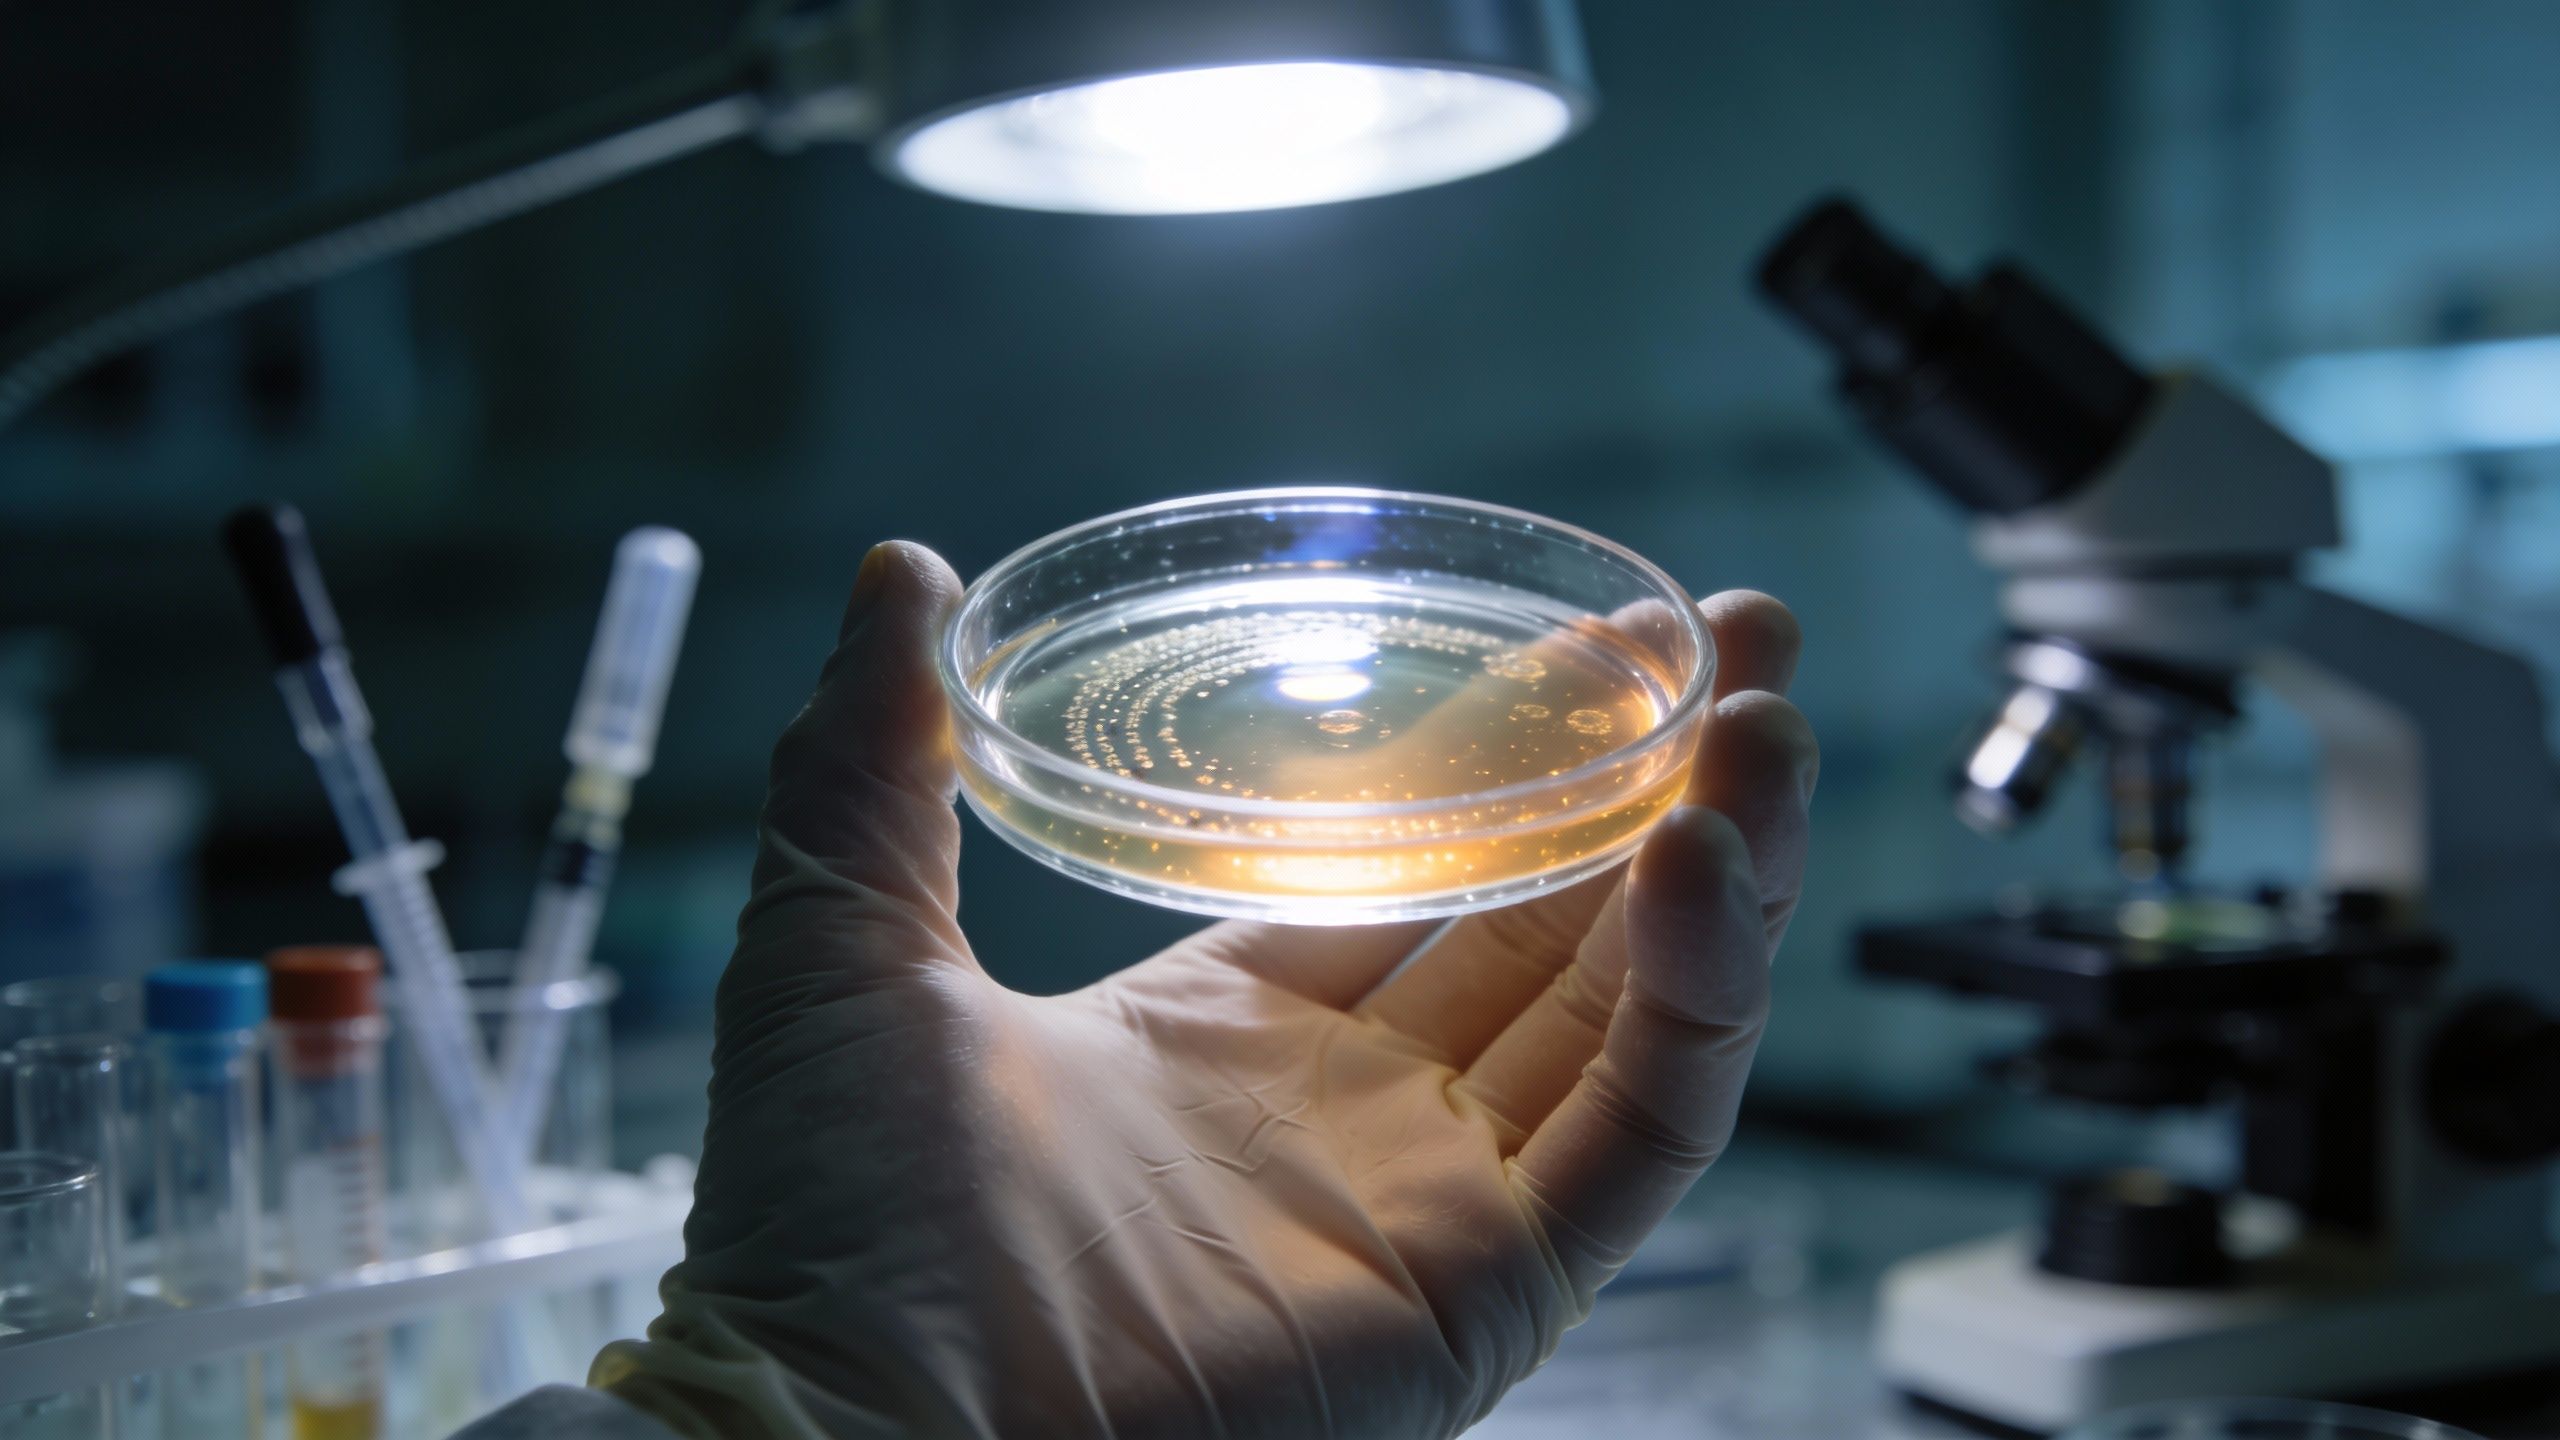

Quand la vie reprend ses droits là où on ne l’attendait plus
On a souvent cette image un peu simpliste de notre corps : une machine bien huilée où, quand une pièce est cassée, elle est simplement jetée. C’est ce qu’on nous a appris, n’est-ce pas ? Une cellule abîmée reçoit un signal, et hop, elle s’élimine. C’est propre, net, sans bavure. Mais voilà que la science vient, comme souvent, bousculer nos certitudes avec une découverte assez troublante, je dois dire.
Il semblerait que la frontière entre la fin d’une cellule et son renouveau ne soit pas si étanche. Des chercheurs ont mis le doigt sur un phénomène inattendu : certaines cellules, pourtant programmées pour disparaître, font de la résistance. Et elles ne font pas que survivre, non… elles se mettent au travail pour réparer les dégâts. C’est un peu comme si les ouvriers qu’on pensait renvoyer chez eux décidaient finalement de reconstruire la maison. Ce mécanisme, encore mal compris il y a peu, pourrait bien tout changer dans notre façon de soigner les tissus abîmés, voire nous aider à mieux comprendre cette fichue maladie qu’est le cancer.
Le mystère des cellules DARE : des survivantes au service de la réparation

Tout commence au Weizmann Institute of Science, en Israël. C’est là qu’une équipe de chercheurs a décidé d’observer ce qui se passe quand on agresse un organisme vivant, en l’occurrence des larves de drosophile — vous savez, cette petite mouche du vinaigre qu’on retrouve souvent en été. Ils ont irradié ces larves pour voir comment elles allaient s’en remettre. Logiquement, certains éléments biologiques ont activé une enzyme bien particulière : la caspase. Pour faire simple, c’est le déclencheur habituel du suicide cellulaire interne. Une fois activée, la cellule est censée s’éteindre.
Mais, surprise… certaines de ces structures ont survécu. Elles ont refusé de mourir. Pire — ou mieux, selon le point de vue —, elles sont entrées dans un cycle de prolifération rapide. Les scientifiques, probablement étonnés par ce qu’ils voyaient, ont baptisé ces résistantes DARE, un acronyme pour Dronc-Activating Regenerating Cells (cellules régénératrices activant la Dronc). Et le plus beau, c’est qu’elles ne bossent pas seules. Selon un article relayé par ScienceAlert, ces cellules DARE recrutent des voisines, appelées NARE, qui elles n’avaient reçu aucun signal de mort. Ensemble, elles forment une sorte d’équipe de choc pour coordonner la réparation de la zone abîmée.
Le résultat est assez bluffant. La zone réparée ne revient pas simplement à la normale ; elle devient plus costaude. Après une seconde irradiation, les descendantes de ces cellules DARE étaient nettement plus coriaces. Les chiffres sont là : elles se montraient sept fois plus difficiles à détruire que les cellules d’origine. C’est fascinant, mais ça me fait aussi un peu froid dans le dos, car ce comportement de « super-résistance » rappelle furieusement celui de certaines tumeurs qui reviennent après un traitement. Il y a là un lien évident entre régénération et survie accrue qu’il va falloir surveiller de près.
Au cœur de l’ADN : quand la manipulation génétique s’en mêle

Bien sûr, la survie de la cellule n’est qu’une partie de l’équation. Pour que tout fonctionne, il faut aussi que la machinerie interne suive, et là, on parle de contrôler l’ADN avec une précision d’orfèvre. La régénération repose sur une capacité vitale de l’organisme : réparer l’ADN de façon ciblée sans faire n’importe quoi, un processus qu’on appelle la recombinaison homologue. C’est essentiel pour éviter les mutations.
Une autre étude, publiée cette fois dans Scientific Reports, a voulu creuser ce sujet. Les chercheurs ont sorti l’artillerie lourde avec CRISPR/Cas9, cet outil révolutionnaire — une sorte de ciseaux moléculaires — qui permet de modifier le génome. Leur but ? Insérer de longs fragments d’ADN dans des cellules de souris. Mais soyons honnêtes, ce genre d’intervention reste un casse-tête : le taux de réussite est souvent faible et ça dépend de trop de paramètres internes capricieux.
Pour donner un coup de pouce à la nature, les scientifiques ont eu une idée ingénieuse : ajouter deux substances spécifiques :
- Le nocodazole, qui va bloquer la division cellulaire à un moment très précis.
- La RNase HII, une autre substance qui aide à corriger les petites coquilles lors de la copie de l’ADN.
Et ça a marché. Ensemble, ces ajouts ont permis une bien meilleure intégration du matériel génétique, et les cellules sont restées en bon état après la manipulation. C’est prometteur, car ces résultats pourraient un jour nous permettre de réparer des tissus humains ou de corriger des maladies génétiques qui semblaient incurables.
Conclusion : Un espoir immense, mais une prudence nécessaire

Alors, que doit-on penser de tout ça ? Cette régénération cellulaire, maintenant qu’on commence à mieux la cerner, ressemble à une arme à double tranchant. D’un côté, les cellules DARE sont des héroïnes : elles survivent à l’impossible pour reconstruire nos tissus. De l’autre, leur obstination à ne pas mourir et leur résistance renforcée rappellent étrangement les mécanismes des cancers. Stimuler ces cellules pourrait nous aider à cicatriser plus vite après une blessure, c’est vrai. Mais à l’inverse, il faudrait peut-être bloquer leur activation pour empêcher une tumeur de rechuter après une radiothérapie.
On n’y est pas encore tout à fait, mais ces recherches ouvrent des portes incroyables. Que ce soit pour la thérapie génique ou la médecine régénérative, comprendre comment certaines cellules décident de « revenir à la vie » change la donne. La régénération n’est plus juste un processus biologique passif, elle pourrait devenir un véritable levier thérapeutique. Il faudra juste apprendre à la doser finement.
Créé par des humains, assisté par IA.
Pourquoi des cellules censées mourir décident soudain de nous sauver
Ce contenu a été créé avec l'aide de l'IA.